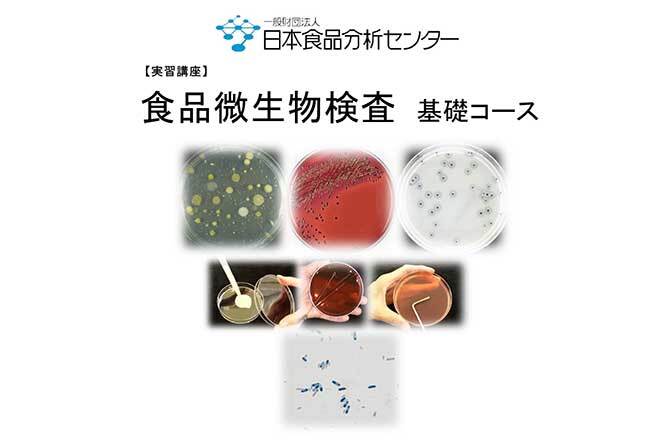
実習講座　食品微生物検査　基礎コース

注目のキーワード
各展示会・セミナーの内容は変更になる可能性があります。最新の開催予定については、主催企業サイトをご確認ください。

【戦略で差がつく】“第一想起”を獲得するインフルエンサーマーケ戦略
開催
:2025年11月12日(水)11:00~12:00
会場
:オンライン

JFフードサービスパートナーズ商談会2025
開催
:2025年11月12日(水)10:00~17:00
会場
:TOCビル・五反田 13階
実習講座 食品微生物検査 基礎コース
開催
:2025年11月13日(木)10:00~18:30、2025年11月14日(金)9:30~16:30
会場
:一般財団法人日本食品分析センター 大阪支所

地方銀行フードセレクション2025
開催
:2025年11月13日(木)11:00~18:00、2025年11月14日(金)10:00~16:00
会場
:東京ビッグサイト 西展示棟1・2ホール

農林水産省:高騰するコスト環境下における「食料システム法」の実務対応
開催
:2025年11月14日(金)9:30~11:30
会場
:JPIカンファレンススクエア

大阪開催【食品加工技術展2025】出展企業募集
開催
:2025年11月14日(金)10:30~16:30
会場
:大阪産業創造館3F・4F(大阪市中央区本町1-4-5)

【農林水産省 令和7年度農林水産物・食品輸出促進対策事業】食品輸出支援セミナー 鳥取会場
開催
:2025年11月14日(金)13:00~16:00
会場
:米子コンベンションセンター 第4会議室

食品をより安全にするための5つの鍵 ~適切な管理手法の実現のために~
開催
:2025年11月17日(月)15:00~15:30
会場
:オンライン(ZOOMウェビナー)

常識を疑え!無料でできるBtoBプラットフォーム受発注の色々
開催
:2025年11月18日(火)14:00~15:00
会場
:オンライン(Zoom)

『インフォマートのデータ活用セミナー 』 原価率1%改善と1年で7店舗出店に学ぶ、"データ活用"と"仕組み化"による利益向上戦略
開催
:2025年11月18日(火) 14:30~16:30
会場
:オンライン(Zoom)

アルゴリズムから紐解く、本質的なX運用
開催
:2025年11月18日(火)11:00~12:00
会場
:オンライン

フードプロフェッショナルカンファレンス2025 vol.3
開催
:2025年11月20日(木)14:30~16:30
会場
:ZOOM・オンライン
注目ノウハウBOOK

飲食店のデータ発注による利益改善策
飲食店が電話やFAXで発注をしていては、売上に対してかかる原価や実際の利益が、正確に把握できない。


